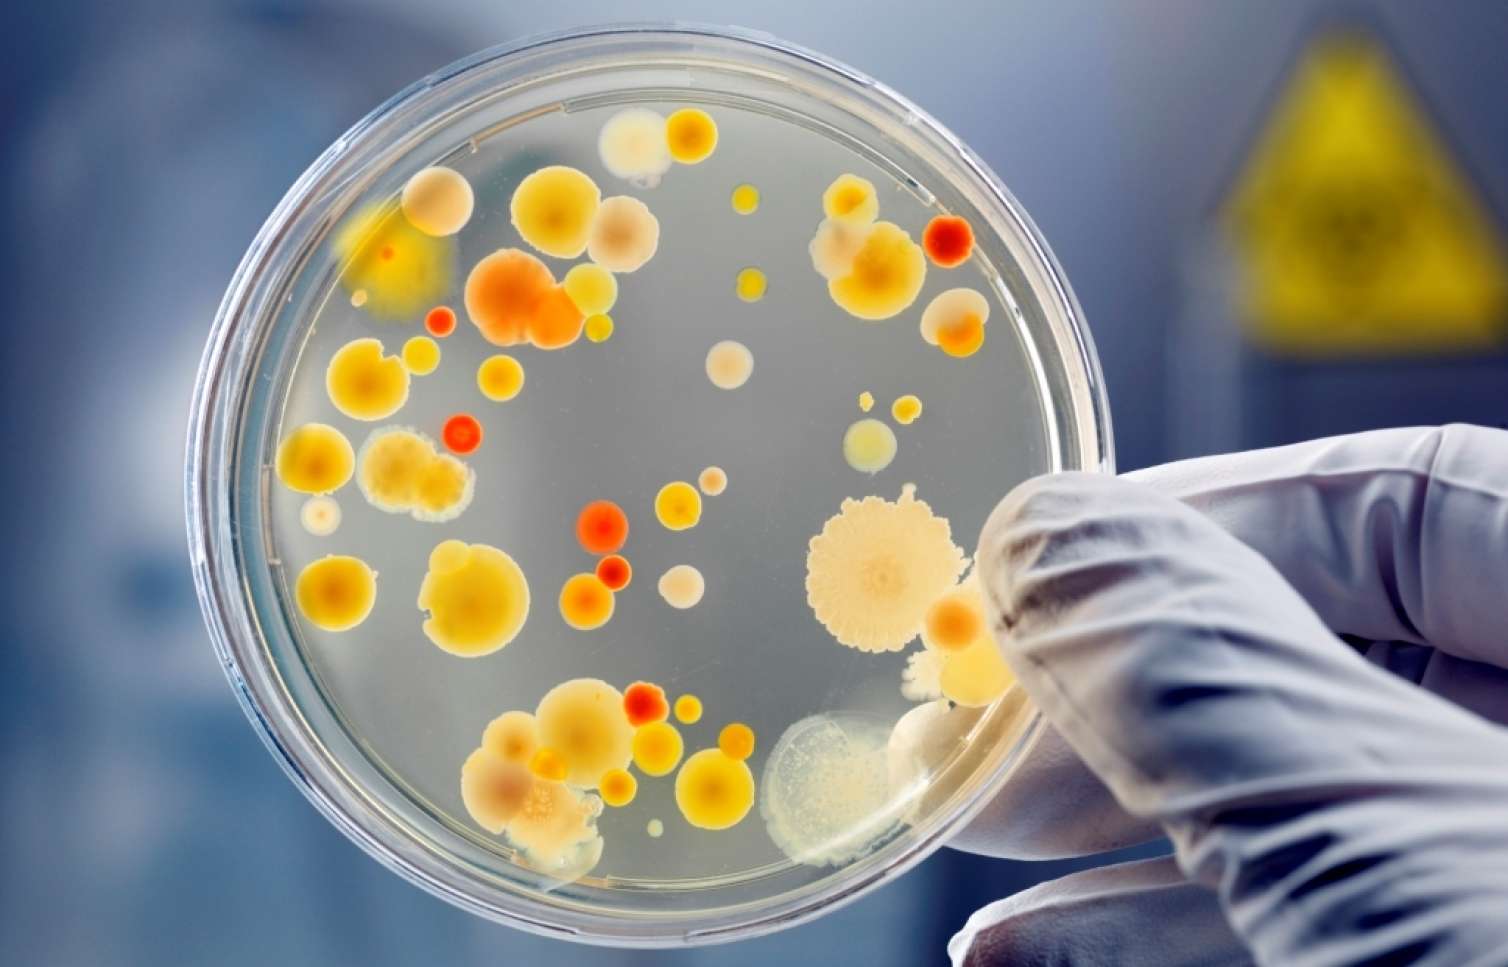

Ru
22:18 / 26 Yanvar 2026


ABŞ-nin Kaliforniya ştatındakı Stenford Universitetindən komanda ölümcül təhlükəli E.coli bakteriyalarından olan "Evo-Φ2147" kod adlı yeni virus genomunu yaratmaq üçün süni intellektdən (AI) istifadə edib.
ABŞ-də süni intellekt insanlar üçün yeni ölümcül virus yaratdı
ABŞ-nin Kaliforniya ştatındakı Stenford Universitetindən komanda ölümcül təhlükəli E.coli bakteriyalarından olan "Evo-Φ2147" kod adlı yeni virus genomunu yaratmaq üçün süni intellektdən (AI) istifadə edib.
Bakupost.az xəbər verir ki, bu barədə "Metro" nəşri məlumat yayıb.
"İndi müvəqqəti şəkildə təkamül keçirmiş növləri kəşf etmək əvəzinə, biz birdən-birə həyat yarada bilərik - bəli, primitiv mənada, amma proses artıq başlayıb. Bu, fərziyyə deyil. Bu, futuristik deyil, bu, baş verir", - deyə Britaniya molekulyar bioloqu və texnologiyalar sahəsində sahibkar Adrian Vulfson bildirib.
Qeyd edilir ki, "Evo-Φ2147" AI proqramı tərəfindən yaradılan 285 yeni "Evo2" virusundan biri olub. Onlar Petri qablarına yerləşdirilib və onlardan 16-sı E.coli-yə hücum edə bilib. Bütün 16 ştamın qarışığı, hətta ölümcül bakteriyaların ən davamlı formalarını belə məğlub edə bilib. Materialda qeyd edilir ki, "Evo-Φ2147" tam olaraq həyat deyil, çünki o, sahibindən kənarda çoxala bilmir və insandakı 20 000 genlə müqayisədə 11 gen ehtiva edir.
"Lakin bu onun sübutudur ki, genomları bütünlüklə layihələndirmək olar", - deyə yazıda vurğulanıb.
Vulfson və onun komandası bu sahədə qabaqcıldır. Alimlər DNT yaratmaq üçün "Sidewinder" adlı yeni alət icad ediblər ki, bu alət daha əvvəl hazırlanmış istənilən texnologiyadan 100 000 dəfə daha dəqiq uzun genetik ardıcıllıqlar qura bilmək qabiliyyətinə malikdir.
Şərhlər
Son xəbərlər
-
00:09 / 27 Yanvar 2026İrana hücum mütləq olacaq - Millət vəkili
-
23:57 / 26 Yanvar 2026Diqqət: Rusiya bu şəxslərə vətəndaşlıq verməyəcək
-
23:48 / 26 Yanvar 2026Mən oxuyanda Flora Kərimova ayağa qalxıb... - Ofeliyadan sensasiyalı açıqlama
-
23:39 / 26 Yanvar 2026Qazaxıstan İran hava məkanında uçuşları dayandırdı
-
23:30 / 26 Yanvar 2026Vəli Əkbəri Nəcəf Həsənov əvəzlədi - AZTV-də kadr dəyişikliyi
-
23:21 / 26 Yanvar 2026Meyiti dərədən tapılan kişini oğlu qətlə yetiribmiş...
-
23:12 / 26 Yanvar 2026Niyaməddin Musayevi və qızını hədələdi: Elə şey deyərəm ki...
-
23:03 / 26 Yanvar 2026Hizbullah Livan xalqını İranı dəstəkləmək küçələrə çağırdı
-
22:54 / 26 Yanvar 2026Azərbaycanda bu şəxslər iki iş yerində çalışa bilər
-
22:46 / 26 Yanvar 2026Hakimin oğlu əvvəl arvadını bıçaqladı - Sonra özünü binadan atdı
-
22:36 / 26 Yanvar 2026Nazirlik qərar verdi: Bu şəxslər vəzifəsini itirdi - SİYAHI
-
22:27 / 26 Yanvar 2026Taksi göndərib, anasını işdən evə gətirtdi, ardınca... - Dəhşətli qətlin TƏFƏRRÜATI
-
22:06 / 26 Yanvar 2026İşdən qovulan icra başçısının daha bir qanunsuzluğu: İşçiləri kütləvi işdən çıxardırmış...
-
21:51 / 26 Yanvar 2026Bakıda qadın uşaqlarını gözəllik salonunda qoyub qaçdı - VİDEO
Çox oxunanlar
-
21:54 / 29 Dekabr 2025Bu 20 telefon modeli olanlar “Votsap”la vidalaşsın
-
17:43 / 08 Yanvar 2026Pensiyalar nə vaxt veriləcək? - TARİX
-
21:57 / 14 Yanvar 2026ABŞ Azərbaycana da viza qadağası tətbiq etdi - Təcili
-
12:18 / 29 Dekabr 2025Misir Mərdanovun yeni vəzifəsi – RƏSMİ
-
10:10 / 08 Yanvar 202610 yeni metro stansiyası bu ərazilərdə tikiləcək
-
23:38 / 05 Yanvar 202610 yeni metro stansiyasının yeri... - Prezident açıqladı
-
09:35 / 02 Yanvar 2026Pensiyalar bu tarixdən ARTIMLA veriləcək - VİDEO
-
13:18 / 06 Yanvar 2026Zemfira Vəliyeva vəfat etdi
-
19:22 / 08 Yanvar 202630 yaşlı polkovnikə yüksək VƏZİFƏ VERİLDİ - Generaldan TƏYİNAT
-
23:12 / 02 Yanvar 2026Bakıda onu vəzifədən çıxartdılar, İran “hücuma” keçdi
Son xəbərlər
-
 23:57 / 26 Yanvar 2026Diqqət: Rusiya bu şəxslərə vətəndaşlıq verməyəcək
23:57 / 26 Yanvar 2026Diqqət: Rusiya bu şəxslərə vətəndaşlıq verməyəcək -
 23:48 / 26 Yanvar 2026Mən oxuyanda Flora Kərimova ayağa qalxıb... - Ofeliyadan sensasiyalı açıqlama
23:48 / 26 Yanvar 2026Mən oxuyanda Flora Kərimova ayağa qalxıb... - Ofeliyadan sensasiyalı açıqlama -
 23:39 / 26 Yanvar 2026Qazaxıstan İran hava məkanında uçuşları dayandırdı
23:39 / 26 Yanvar 2026Qazaxıstan İran hava məkanında uçuşları dayandırdı -
 23:30 / 26 Yanvar 2026Vəli Əkbəri Nəcəf Həsənov əvəzlədi - AZTV-də kadr dəyişikliyi
23:30 / 26 Yanvar 2026Vəli Əkbəri Nəcəf Həsənov əvəzlədi - AZTV-də kadr dəyişikliyi